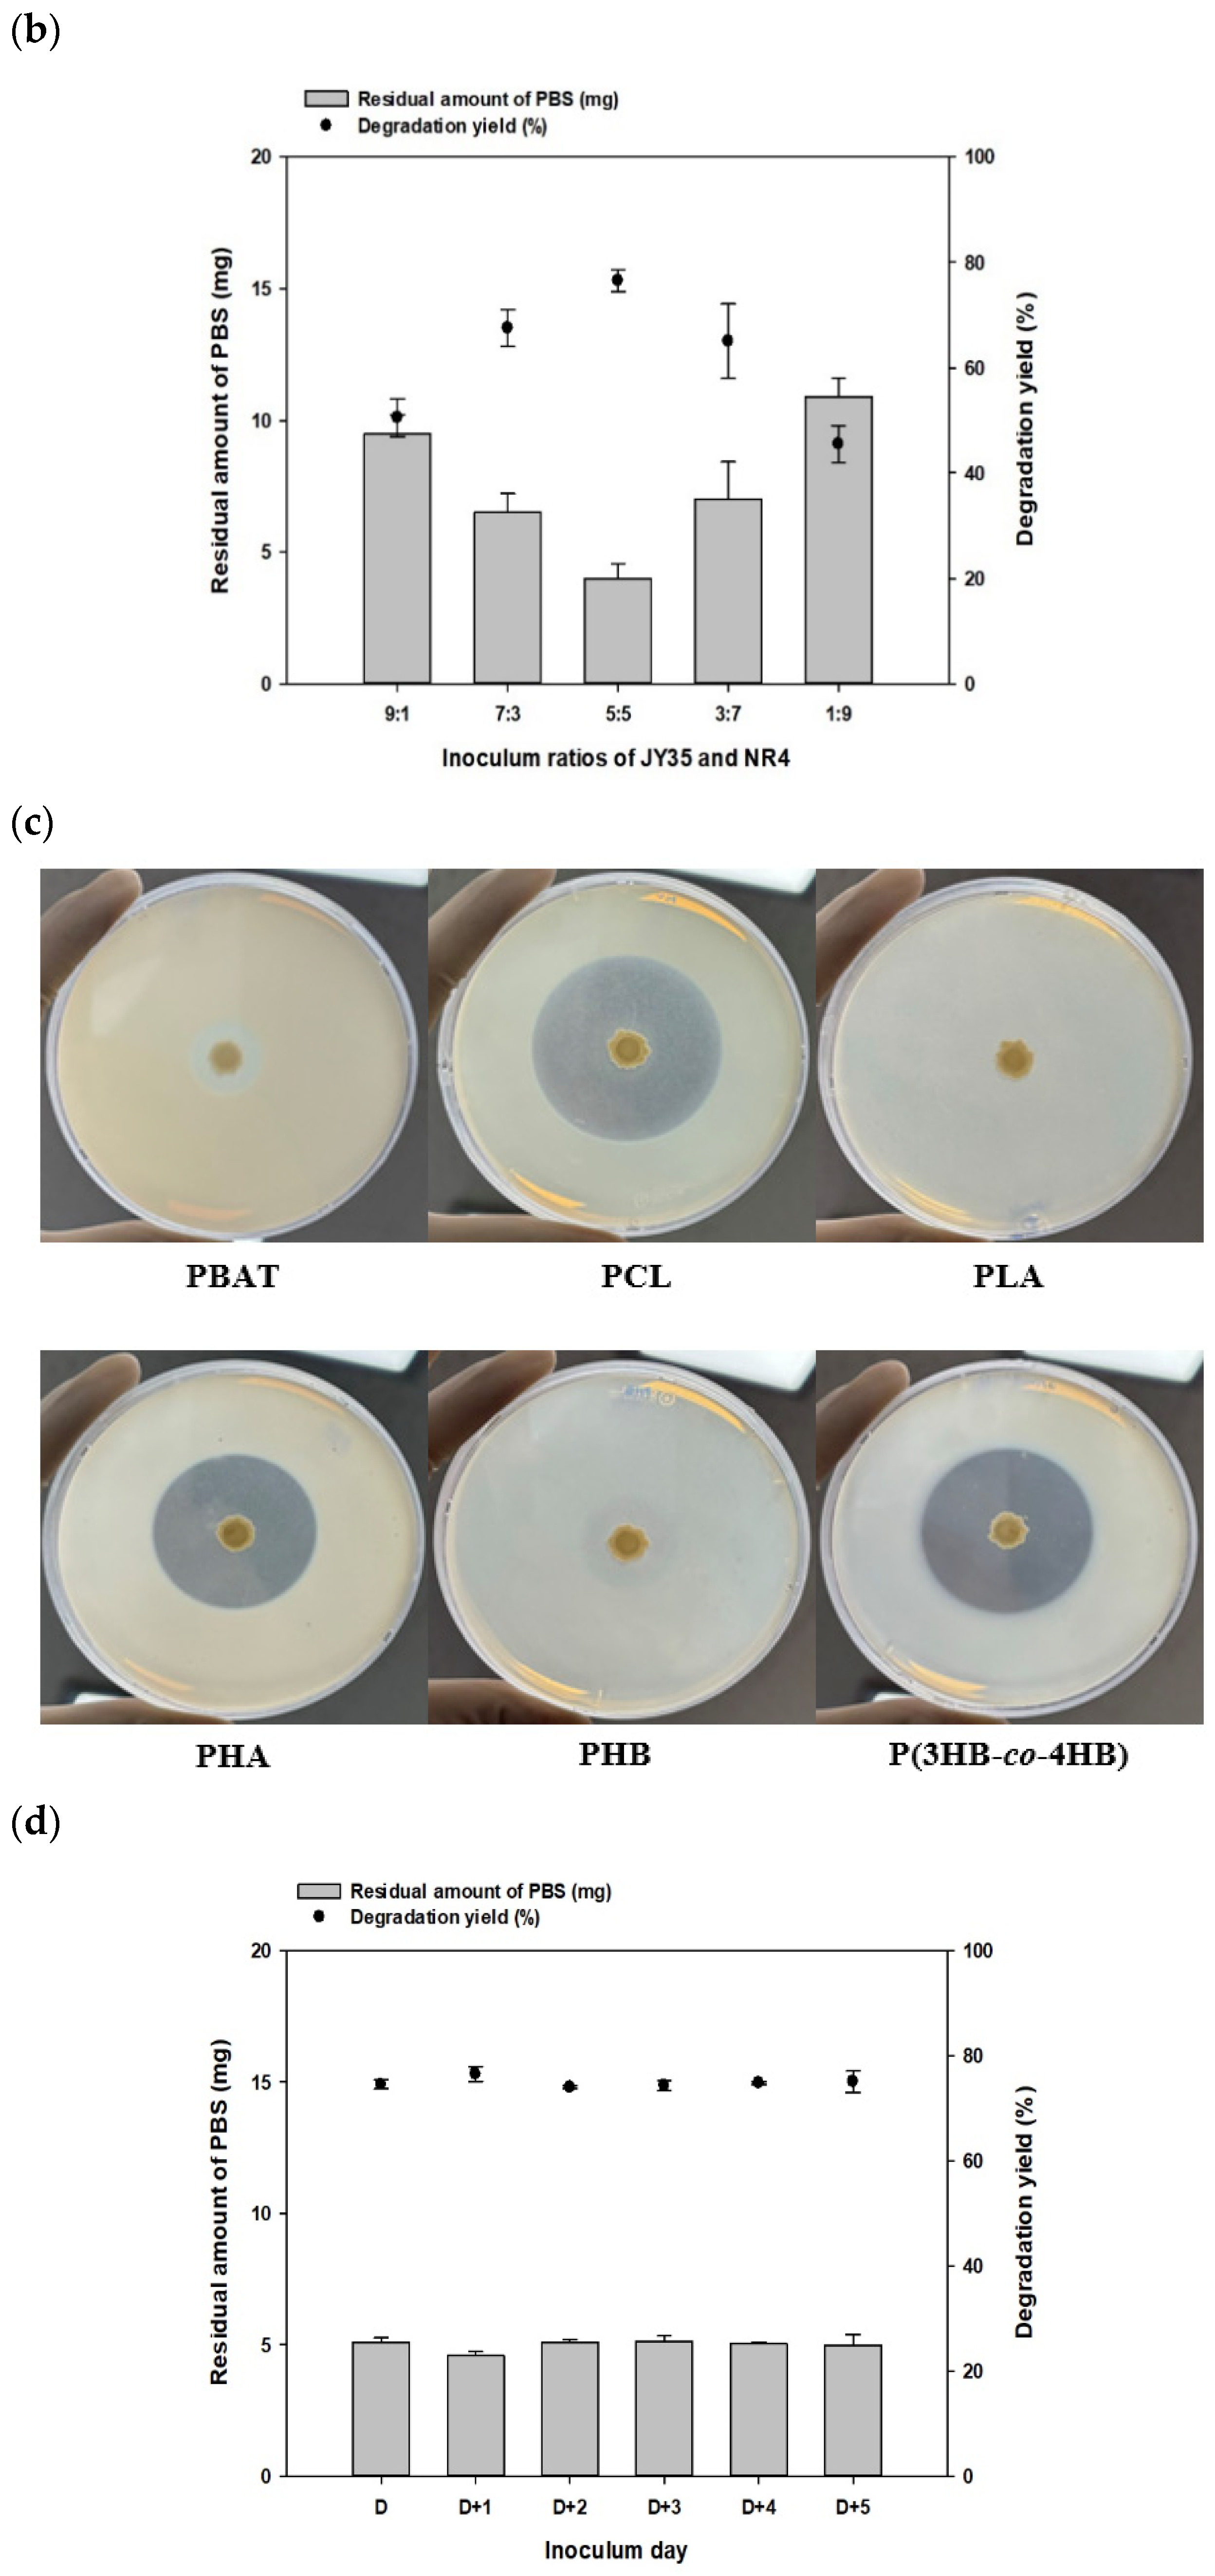
Polymers 16 00651 g003b

Reproducible Polybutylene Succinate (PBS)-Degrading Artificial Consortia by Introducing the Least Type of PBS-Degrading Strains
Abstract
1. Introduction
2. Materials and Methods
2.1. Chemicals
2.2. Formation of PBS Film and Solid Plate Containing Bioplastics Using Solvent Casting
2.3. Formulating Microbial Consortia for PBS Degradation
2.4. Quantification of Degradation Yield through Liquid Culture
2.5. Monitoring of the Clear Zone by Solid Culture
2.6. Quantification of Protein Concentration in Microbial Pre-Culture Supernatant through Bradford Assay
2.7. Analysis of PBS Degradation Yield Using Gas Chromatography–Mass Spectrometry (GC–MS)
2.8. Derivatization Method
2.9. Characterization and Analysis of PBS Films after Degradation
2.9.1. Scanning Electron Microscopy (SEM)
2.9.2. Fourier Transform Infrared Spectroscopy (FT-IR)
2.9.3. Gel Permeation Chromatography (GPC)
3. Results and Discussion
3.1. Evaluation of Degrading Ability by Artifitial PBS Degrading Bacterial Consortia
3.2. Comparison of Single Strain and Consortia Degradability on PBS in Solid Media and Measurement of Secreted Protein
3.3. Degradation of PBS Film by Consortia over Time and Optimization of Strain Ratio
3.4. Analysis of Chemical and Physical Properties Changes by Consortium
3.4.1. Physical Property Changes of PBS Films Following Degradation by Consortium
3.4.2. Chemical Property Changes of PBS Films following Degradation by Consortium
4. Conclusions
Supplementary Materials
Author Contributions
Funding
Institutional Review Board Statement
Data Availability Statement
Conflicts of Interest
References
- Sharma, H.; Neelam, D.K. Understanding Challenges Associated with Plastic and Bacterial Approach toward Plastic Degradation. J. Basic Microbiol. 2023, 63, 292–307. [Google Scholar] [CrossRef]
- Liu, L.; Xu, M.; Ye, Y.; Zhang, B. On the Degradation of (Micro)Plastics: Degradation Methods, Influencing Factors, Environmental Impacts. Sci. Total Environ. 2022, 806, 151312. [Google Scholar] [CrossRef] [PubMed]
- Maalouf, A.; Agamuthu, P. Waste Management Evolution in the Last Five Decades in Developing Countries–A Review. Waste Manag. Res. 2023, 41, 1420–1434. [Google Scholar] [CrossRef] [PubMed]
- Ivar Do Sul, J.A.; Costa, M.F. The Present and Future of Microplastic Pollution in the Marine Environment. Environ. Pollut. 2014, 185, 352–364. [Google Scholar] [CrossRef]
- Ward, C.P.; Reddy, C.M. We Need Better Data about the Environmental Persistence of Plastic Goods. Proc. Natl. Acad. Sci. USA 2020, 117, 14618–14621. [Google Scholar] [CrossRef] [PubMed]
- Chamas, A.; Moon, H.; Zheng, J.; Qiu, Y.; Tabassum, T.; Jang, J.H.; Abu-Omar, M.; Scott, S.L.; Suh, S. Degradation Rates of Plastics in the Environment. ACS Sustain. Chem. Eng. 2020, 8, 3494–3511. [Google Scholar] [CrossRef]
- Haider, T.P.; Völker, C.; Kramm, J.; Landfester, K.; Wurm, F.R. Kunststoffe Der Zukunft? Der Einfluss von Bioabbaubaren Polymeren Auf Umwelt Und Gesellschaft. Angew. Chem. 2019, 131, 50–63. [Google Scholar] [CrossRef]
- Sudesh, K.; Iwata, T. Sustainability of Biobased and Biodegradable Plastics. Clean 2008, 36, 433–442. [Google Scholar] [CrossRef]
- Rivero, C.P.; Hu, Y.; Kwan, T.H.; Webb, C.; Theodoropoulos, C.; Daoud, W.; Lin, C.S.K. Bioplastics from Solid Waste. Curr. Dev. Biotechnol. Bioeng. Solid Waste Manag. 2017, 1–26. [Google Scholar] [CrossRef]
- Folino, A.; Karageorgiou, A.; Calabrò, P.S.; Komilis, D. Biodegradation of Wasted Bioplastics in Natural and Industrial Environments: A Review. Sustainability 2020, 12, 6030. [Google Scholar] [CrossRef]
- Zhu, J.; Wang, C. Biodegradable Plastics: Green Hope or Greenwashing? Mar. Pollut. Bull. 2020, 161, 111774. [Google Scholar] [CrossRef]
- Atiwesh, G.; Mikhael, A.; Parrish, C.C.; Banoub, J.; Le, T.A.T. Environmental Impact of Bioplastic Use: A Review. Heliyon 2021, 7, e07918. [Google Scholar] [CrossRef]
- Nanda, S.; Patra, B.R.; Patel, R.; Bakos, J.; Dalai, A.K. Innovations in Applications and Prospects of Bioplastics and Biopolymers: A Review. Environ. Chem. Lett. 2022, 20, 379–395. [Google Scholar] [CrossRef]
- Zeng, J.B.; Li, Y.D.; Zhu, Q.Y.; Yang, K.K.; Wang, X.L.; Wang, Y.Z. A Novel Biodegradable Multiblock Poly(Ester Urethane) Containing Poly(l-Lactic Acid) and Poly(Butylene Succinate) Blocks. Polymer 2009, 50, 1178–1186. [Google Scholar] [CrossRef]
- Rafiqah, S.A.; Khalina, A.; Harmaen, A.S.; Tawakkal, I.A.; Zaman, K.; Asim, M.; Nurrazi, M.N.; Lee, C.H. A Review on Properties and Application of Bio-based Poly(Butylene Succinate). Polymers 2021, 13, 1436. [Google Scholar] [CrossRef] [PubMed]
- Tan, B.; Bi, S.; Emery, K.; Sobkowicz, M.J. Bio-Based Poly(Butylene Succinate-Co-Hexamethylene Succinate) Copolyesters with Tunable Thermal and Mechanical Properties. Eur. Polym. J. 2017, 86, 162–172. [Google Scholar] [CrossRef]
- Platnieks, O.; Gaidukovs, S.; Kumar Thakur, V.; Barkane, A.; Beluns, S. Bio-Based Poly (Butylene Succinate): Recent Progress, Challenges and Future Opportunities. Eur. Polym. J. 2021, 161, 110855. [Google Scholar] [CrossRef]
- Cheroennet, N.; Pongpinyopap, S.; Leejarkpai, T.; Suwanmanee, U. A Trade-off between Carbon and Water Impacts in Bio-Based Box Production Chains in Thailand: A Case Study of PS, PLAS, PLAS/Starch, and PBS. J. Clean Prod. 2017, 167, 987–1001. [Google Scholar] [CrossRef]
- Zaaba, N.F.; Jaafar, M. A Review on Degradation Mechanisms of Polylactic Acid: Hydrolytic, Photodegradative, Microbial, and Enzymatic Degradation. Polym. Eng. Sci. 2020, 60, 2061–2075. [Google Scholar] [CrossRef]
- Abe, M.; Kobayashi, K.; Honma, N.; Nakasaki, K. Microbial Degradation of Poly(Butylene Succinate) by Fusarium Solani in Soil Environments. Polym. Degrad. Stab. 2010, 95, 138–143. [Google Scholar] [CrossRef]
- Samaimai, S.; Krajangsang, S.; Kitpreechavanich, V.; Borthong, J.; Lomthong, T. Degradation of Poly(Butylene Succinate) and Poly(Butylene Succinate)/Poly(Lactide) Blends Using Serine Protease Produced from Laceyella Sacchari LP175. Trends Sci. 2021, 18, 37. [Google Scholar] [CrossRef]
- Kim, S.H.; Cho, J.Y.; Cho, D.H.; Jung, H.J.; Kim, B.C.; Bhatia, S.K.; Park, S.H.; Park, K.; Yang, Y.H. Acceleration of Polybutylene Succinate Biodegradation by Terribacillus Sp. JY49 Isolated from a Marine Environment. Polymers 2022, 14, 3978. [Google Scholar] [CrossRef] [PubMed]
- Mei, X.; Tian, C.; Dong, Q.; Liang, Y. Influencing Factors and Process on in Situ Degradation of Poly(Butylene Succinate) Film by Strain Bionectria ochroleuca BFM-X1 in Soil. J. Environ. Prot. 2012, 03, 523–532. [Google Scholar] [CrossRef]
- Esmaeili, A.; Pourbabaee, A.A.; Alikhani, H.A.; Shabani, F.; Esmaeili, E. Biodegradation of Low-Density Polyethylene (LDPE) by Mixed Culture of Lysinibacillus Xylanilyticus and Aspergillus Niger in Soil. PLoS ONE 2013, 8, e71720. [Google Scholar] [CrossRef] [PubMed]
- Zhao, J.H.; Wang, X.Q.; Zeng, J.; Yang, G.; Shi, F.H.; Yan, Q. Biodegradation of Poly(Butylene Succinate) in Compost. J. Appl. Polym. Sci. 2005, 97, 2273–2278. [Google Scholar] [CrossRef]
- Skariyachan, S.; Taskeen, N.; Kishore, A.P.; Krishna, B.V.; Naidu, G. Novel Consortia of Enterobacter and Pseudomonas Formulated from Cow Dung Exhibited Enhanced Biodegradation of Polyethylene and Polypropylene. J. Environ. Manag. 2021, 284, 112030. [Google Scholar] [CrossRef]
- Pacheco, A.R.; Moel, M.; Segrè, D. Costless Metabolic Secretions as Drivers of Interspecies Interactions in Microbial Ecosystems. Nat. Commun. 2019, 10, 103. [Google Scholar] [CrossRef]
- Skariyachan, S.; Megha, M.; Kini, M.N.; Mukund, K.M.; Rizvi, A.; Vasist, K. Selection and Screening of Microbial Consortia for Efficient and Ecofriendly Degradation of Plastic Garbage Collected from Urban and Rural Areas of Bangalore, India. Environ. Monit. Assess. 2015, 187, 4174. [Google Scholar] [CrossRef]
- Li, X.; Wu, S.; Dong, Y.; Fan, H.; Bai, Z.; Zhuang, X. Engineering Microbial Consortia towards Bioremediation. Water 2021, 13, 2928. [Google Scholar] [CrossRef]
- Johns, N.I.; Blazejewski, T.; Gomes, A.L.C.; Wang, H.H. Principles for Designing Synthetic Microbial Communities. Curr. Opin. Microbiol. 2016, 31, 146–153. [Google Scholar] [CrossRef]
- Cho, J.Y.; Park, S.L.; Kim, S.H.; Jung, H.J.; Cho, D.H.; Kim, B.C.; Bhatia, S.K.; Gurav, R.; Park, S.H.; Park, K.; et al. Novel Poly(Butylene Adipate-Co-Terephthalate)-Degrading Bacillus Sp. JY35 from Wastewater Sludge and Its Broad Degradation of Various Bioplastics. Waste Manag. 2022, 144, 1–10. [Google Scholar] [CrossRef]
- Shin, N.; Kim, S.H.; Cho, J.Y.; Hwang, J.H.; Kim, H.J.; Oh, S.J.; Park, S.H.; Park, K.; Bhatia, S.K.; Yang, Y.H. Fast Degradation of Polycaprolactone/Poly(Butylene Adipate-Co-Terephthalate) Blends by Novel Bacillus Strain NR4 with Broad Degrading Activity. J. Polym. Environ. 2023, 32, 898–912. [Google Scholar] [CrossRef]
- Ihling, N.; Uhde, A.; Scholz, R.; Schwarz, C.; Schmitt, L.; Büchs, J. Scale-up of a Type I Secretion System in E. coli Using a Defined Mineral Medium. Biotechnol. Prog. 2020, 36, e2911. [Google Scholar] [CrossRef]
- Bhatia, S.K.; Gurav, R.; Choi, T.R.; Han, Y.H.; Park, Y.L.; Park, J.Y.; Jung, H.R.; Yang, S.Y.; Song, H.S.; Kim, S.H.; et al. Bioconversion of Barley Straw Lignin into Biodiesel Using Rhodococcus Sp. YHY01. Bioresour. Technol. 2019, 289, 121704. [Google Scholar] [CrossRef]
- Park, S.L.; Cho, J.Y.; Kim, S.H.; Bhatia, S.K.; Gurav, R.; Park, S.H.; Park, K.; Yang, Y.H. Isolation of Microbulbifer Sp. Sol66 with High Polyhydroxyalkanoate-Degrading Activity from the Marine Environment. Polymers 2021, 13, 4257. [Google Scholar] [CrossRef] [PubMed]
- Pietrogrande, M.C.; Manarini, F.; Quintana, J.B.; Rodil, R.; Villaverde-de-Sáa, E.; Visentin, M. Optimization of an Ultrasound-Assisted Derivatization for GC/MS Analysis of Oxygenated Organic Species in Atmospheric Aerosol. Anal. Bioanal. Chem. 2017, 409, 4279–4291. [Google Scholar] [CrossRef] [PubMed]
- Gómez, M.; Grimes, S.; Fowler, G. Novel Hydrometallurgical Process for the Recovery of Copper from End-of-Life Mobile Phone Printed Circuit Boards Using Ionic Liquids. J. Clean. Prod. 2023, 420, 138379. [Google Scholar] [CrossRef]
- Kulkarni, S.O.; Kanekar, P.P.; Jog, J.P.; Patil, P.A.; Nilegaonkar, S.S.; Sarnaik, S.S.; Kshirsagar, P.R. Characterisation of Copolymer, Poly (Hydroxybutyrate-Co-Hydroxyvalerate) (PHB-Co-PHV) Produced by Halomonas Campisalis (MCM B-1027), Its Biodegradability and Potential Application. Bioresour. Technol. 2011, 102, 6625–6628. [Google Scholar] [CrossRef] [PubMed]
- Ashby, R.D.; Solaiman, D.K.Y. Poly(Hydroxyalkanoate) Biosynthesis from Crude Alaskan Pollock (Theragra Chalcogramma) Oil. J. Polym. Environ. 2008, 16, 221–229. [Google Scholar] [CrossRef]
- Roell, G.W.; Zha, J.; Carr, R.R.; Koffas, M.A.; Fong, S.S.; Tang, Y.J. Engineering Microbial Consortia by Division of Labor. Microb. Cell Factories 2019, 18, 35. [Google Scholar] [CrossRef]
- de Oliveira, T.A.; Barbosa, R.; Mesquita, A.B.S.; Ferreira, J.H.L.; de Carvalho, L.H.; Alves, T.S. Fungal Degradation of Reprocessed PP/PBAT/Thermoplastic Starch Blends. J. Mater. Res. Technol. 2020, 9, 2338–2349. [Google Scholar] [CrossRef]
- Shah, A.A.; Hasan, F.; Hameed, A.; Ahmed, S. Biological Degradation of Plastics: A Comprehensive Review. Biotechnol. Adv. 2008, 26, 246–265. [Google Scholar] [CrossRef]
- Lindström, A.; Albertsson, A.C.; Hakkarainen, M. Quantitative Determination of Degradation Products an Effective Means to Study Early Stages of Degradation in Linear and Branched Poly(Butylene Adipate) and Poly(Butylene Succinate). Polym. Degrad. Stab. 2004, 83, 487–493. [Google Scholar] [CrossRef]
- Kunioka, M.; Ninomiya, F.; Funabashi, M. Biodegradation of Poly(Butylene Succinate) Powder in a Controlled Compost at 58 °C Evaluated by Naturally-Occurring Carbon 14 Amounts in Evolved CO2 Based on the ISO 14855-2 Method. Int. J. Mol. Sci. 2009, 10, 4267–4283. [Google Scholar] [CrossRef] [PubMed]
- Mizuno, S.; Maeda, T.; Kanemura, C.; Hotta, A. Biodegradability, Reprocessability, and Mechanical Properties of Polybutylene Succinate (PBS) Photografted by Hydrophilic or Hydrophobic Membranes. Polym. Degrad. Stab. 2015, 117, 58–65. [Google Scholar] [CrossRef]
- Sim, S.J.; Snell, K.D.; Hogan, S.A.; Stubbe, J.A.; Rha, C.; Sinskey, A.J. PHA Synthase Activity Controls the Molecular Weight and Polydispersity of Polyhydroxybutyrate in Vivo. Nat. Biotechnol. 1997, 15, 63–67. [Google Scholar] [CrossRef] [PubMed]
- Ho, B.T.; Roberts, T.K.; Lucas, S. An Overview on Biodegradation of Polystyrene and Modified Polystyrene: The Microbial Approach. Crit. Rev. Biotechnol. 2018, 38, 308–320. [Google Scholar] [CrossRef] [PubMed]
- Ahn, J.-H.; Kim, J.-H.; Kim, J.-D.; Park, S.; Park, K.H.; Lee, J.-M. Mechanical Behavior of Polymer Foam Reinforced with Silica Aerogel. J. Ocean. Eng. Technol. 2017, 31, 413–418. [Google Scholar] [CrossRef]
- Bo, L.; Guan, T.; Wu, G.; Ye, F.; Weng, Y. Biodegradation Behavior of Degradable Mulch with Poly (Butylene Adipate-Co-Terephthalate) (PBAT) and Poly (Butylene Succinate) (PBS) in Simulation Marine Environment. Polymers 2022, 14, 1515. [Google Scholar] [CrossRef]

| Strain | Temperature | Days of Degradation | Degradation Percentage | Ref. |
|---|---|---|---|---|
| Fusarium solani | - | 14 | 2.8 wt% | [20] |
| Laceyella sacchari LP175 | 50 °C | 2 | 46.5 wt% | [21] |
| Terribacillus goriensis | 30 °C | 10 | 31.4% | [22] |
| Bionectria ochroleuca BFM-X1 | 30 °C | 30 | 60 wt% | [23] |
| Aspergillus versicolor, Penicillium, Bacillus, Thermopolyarpora | - | 90 | 60.7% | [25] |
| Bacillus sp. JY35, Bacillus sp. NR4 | 30 °C | 10 | 76.5% | In this study |
| Strains | Target | Degradability for PBS * | Temperature | Day of Degradation | Degradation Yield (%) | Ref |
|---|---|---|---|---|---|---|
| Bacillus sp. JY35 | PBAT | + | 30 °C | 21 days | 50% | [31] |
| Terribacillus sp. JY49 | PBS | ++ | 30 °C | 10 days | 22.3% | [22] |
| Bacillus sp. NR4 | PCL/PBAT | + | 37 °C | 14 days | 88.3% (PCL 85%, PBAT 15%) | [32] |
| Day | × | × | (PDI) |
|---|---|---|---|
| 0 | 3.87 | 9.49 | 2.45 |
| 3 | 2.19 | 4.60 | 2.10 |
| 5 | 2.10 | 4.53 | 2.15 |
| 7 | 2.08 | 4.28 | 2.06 |
| 10 | 2.01 | 4.06 | 2.05 |
Disclaimer/Publisher’s Note: The statements, opinions and data contained in all publications are solely those of the individual author(s) and contributor(s) and not of MDPI and/or the editor(s). MDPI and/or the editor(s) disclaim responsibility for any injury to people or property resulting from any ideas, methods, instructions or products referred to in the content. |
© 2024 by the authors. Licensee MDPI, Basel, Switzerland. This article is an open access article distributed under the terms and conditions of the Creative Commons Attribution (CC BY) license (https://creativecommons.org/licenses/by/4.0/).
Share and Cite
Shin, N.; Kim, S.H.; Oh, J.; Kim, S.; Lee, Y.; Shin, Y.; Choi, S.; Bhatia, S.K.; Kim, Y.-G.; Yang, Y.-H. Reproducible Polybutylene Succinate (PBS)-Degrading Artificial Consortia by Introducing the Least Type of PBS-Degrading Strains. Polymers 2024, 16, 651. https://doi.org/10.3390/polym16050651
Shin N, Kim SH, Oh J, Kim S, Lee Y, Shin Y, Choi S, Bhatia SK, Kim Y-G, Yang Y-H. Reproducible Polybutylene Succinate (PBS)-Degrading Artificial Consortia by Introducing the Least Type of PBS-Degrading Strains. Polymers. 2024; 16(5):651. https://doi.org/10.3390/polym16050651
Chicago/Turabian StyleShin, Nara, Su Hyun Kim, Jinok Oh, Suwon Kim, Yeda Lee, Yuni Shin, Suhye Choi, Shashi Kant Bhatia, Yun-Gon Kim, and Yung-Hun Yang. 2024. "Reproducible Polybutylene Succinate (PBS)-Degrading Artificial Consortia by Introducing the Least Type of PBS-Degrading Strains" Polymers 16, no. 5: 651. https://doi.org/10.3390/polym16050651
APA StyleShin, N., Kim, S. H., Oh, J., Kim, S., Lee, Y., Shin, Y., Choi, S., Bhatia, S. K., Kim, Y.-G., & Yang, Y.-H. (2024). Reproducible Polybutylene Succinate (PBS)-Degrading Artificial Consortia by Introducing the Least Type of PBS-Degrading Strains. Polymers, 16(5), 651. https://doi.org/10.3390/polym16050651
